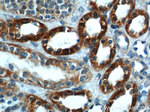
SLC25A6 Antibody in Immunohistochemistry (Paraffin) (IHC (P))
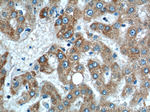
SLC25A6 Antibody in Immunohistochemistry (Paraffin) (IHC (P))

Search
Proteintech
SLC25A6 Polyclonal Antibody
{{$productOrderCtrl.translations['antibody.pdp.commerceCard.promotion.promotions']}}
{{$productOrderCtrl.translations['antibody.pdp.commerceCard.promotion.viewpromo']}}
{{$productOrderCtrl.translations['antibody.pdp.commerceCard.promotion.promocode']}}: {{promo.promoCode}} {{promo.promoTitle}} {{promo.promoDescription}}. {{$productOrderCtrl.translations['antibody.pdp.commerceCard.promotion.learnmore']}}
产品信息
14841-1-AP
种属反应
已发表种属
宿主/亚型
分类
类型
抗原
偶联物
形式
浓度
规格
纯化类型
保存液
内含物
保存条件
运输条件
靶标信息
This gene is a member of the mitochondrial carrier subfamily of solute carrier protein genes. The product of this gene functions as a gated pore that translocates ADP from the mitochondrial matrix into the cytoplasm. The protein is implicated in the function of the permability transition pore complex (PTPC), which regulates the release of mitochondrial products that induce apoptosis. The human genome contains several non-transcribed pseudogenes of this gene.
仅用于科研。不用于诊断过程。未经明确授权不得转售。
生物信息学
蛋白别名: Adenine nucleotide translocator 3; ADP,ATP carrier protein 3; ADP,ATP carrier protein, isoform T2; ADP,ATP carrier protein, liver; ADP.ATP translocase; ADP/ATP translocase 3; ADP/ATP translocator of liver; ANT 2; ANT 3; epididymis secretory sperm binding protein; Mitochondrial S-adenosylmethionine carrier protein; mitochondrial S-adenosylmethionine transporter; S-adenosylmethionine mitochondrial carrier protein; SAM carrier; similar to bovine ADP/ATP translocase T1 mRNA with GenBank Accession Number M24102.1; SLC25A6; solute carrier family 25 (mitochondrial carrier; adenine nucleotide translocator), member 6; Solute carrier family 25 member 26; Solute carrier family 25 member 6; unnamed protein product
基因别名: 4930433D19Rik; 4933433F13Rik; AAC3; ANT; ANT 2; ANT 3; ANT3; ANT3Y; AW557176; CDABP0051; D6Bwg0781e; Samc; Slc25a26; SLC25A6
UniProt ID: (Human) P12236, (Mouse) Q5U680
Entrez Gene ID: (Human) 293, (Mouse) 67582